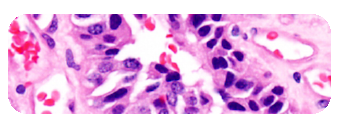

About Us
Founded in 1951, PML is dedicated to continuing its long history of outstanding service and unsurpassed quality. We accomplish this by providing exceptional service in a professional and timely manner using the intellectual strengths and technical expertise of our physicians and staff.